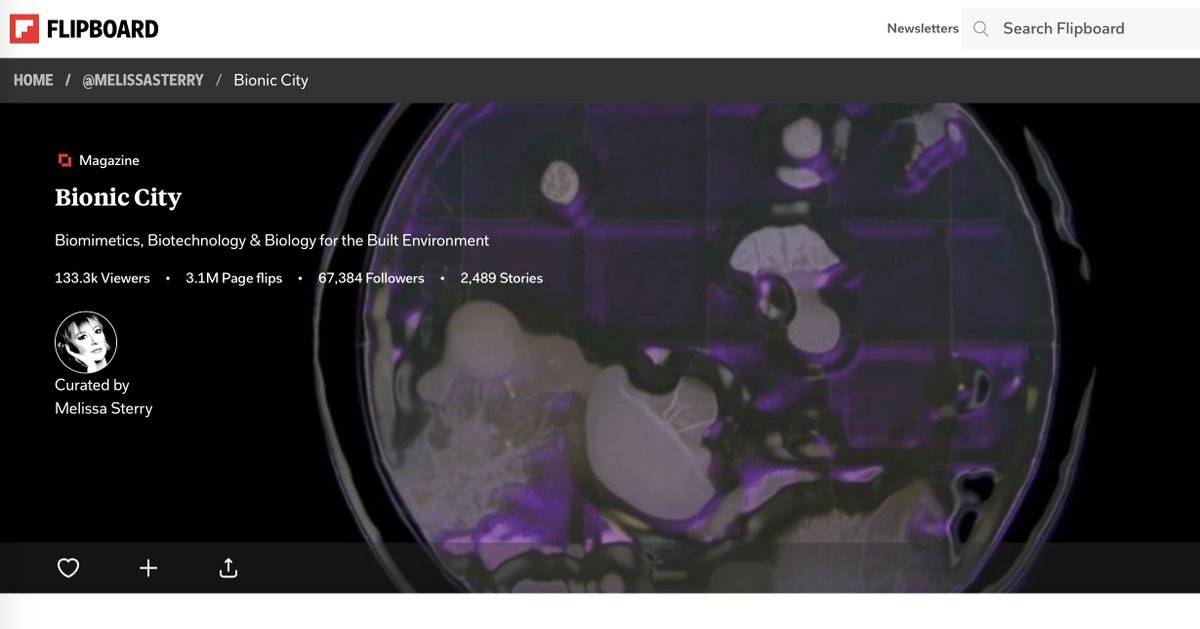
Bionic City tweet media

Great interview with Teo Sandigliano: wevux.com/designed-wilde…
#biodesign #bioreceptivedesign #slowbiodesign #artofnoticing
English
Barbara Pollini
238 posts


@PolliniBarbara
PhD in Biodesign / Assistant Professor in Biodesign Integration @Aalto #sustainabledesign #biodesign and #materialdesign are my polar stars!